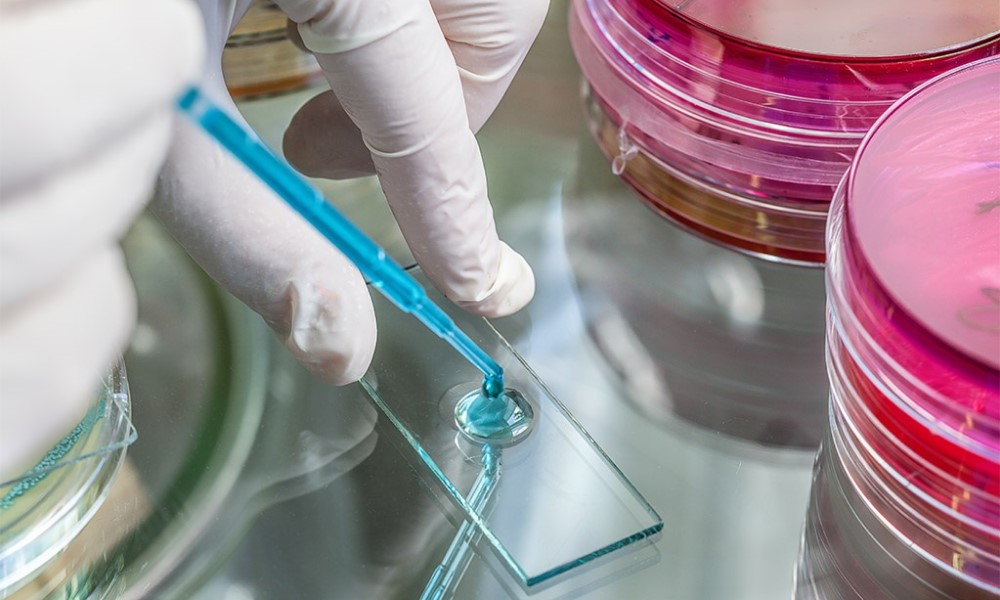
Alarm u Hrvatskoj: U zagrebačkoj bolnici se pojavila opasna bolest

FOTO: Društvene mreže
FOTO: Društvene mreže
Alarm u Hrvatskoj: U zagrebačkoj bolnici se pojavila opasna bolest
18.06.2024. | 12:22Pet pacijenata, hospitalizovanih u KBC Zagreb, na lokaciji Rebro, zarazilo se legionelom, potvrđeno je hrvatskim medijima iz KBC-a.
Nakon što je ustanovljeno da imaju zaražene pacijente, od čega je dvoje u teškom stanju, krenulo se u istragu odakle je krenula zaraza.
“Odmah smo alarmirali Hrvatski zavod za javno zdravstvo koji je napravio sve analize i bakterija je izolirana u vodovodnom sustavu. U ovom trenu je u tijeku pasterizacija, odnosno ispušta se vrela voda iz svih slavina u bolnici”, kaže prof.dr. Milivoj Novak, pomoćnik direktora za kvalitet.
Znakove bolesti je pokazalo pet pacijenata, od kojih je dvoje u teškom stanju.
“Riječ je o pacijentima koji su teško bolesni od osnovne bolesti tako da je Legionella drastično pogoršala njihovo stanje”, govori Novak.





